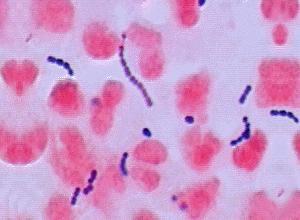

Flashcards with images
Pinned to
5680
6
0
No tags specified
|
|
Created by mattpalmer789
over 10 years ago
|
|
Close
|
|
Created by mattpalmer789
over 10 years ago
|
|

Which of the following best describes this Gram stain of a sputum specimen?

This cell is most likely a...

The Gram-positive objects in this image are most likely...

This image of a low power field from a sputum Gram stain suggests that...

This Gram stain of a male urethral discharge is suggestive of...

This Gram stain of a female genital specimen is...

This image of a Gram stain of a cerebrospinal fluid specimen taken from a two year old child with a fever is best described as ...?

This image contains the following…
A) White blood cell(s)
B) Epithelial cell(s)
C) Gram-positive bacteria
D) All of the above

This image of a low power field from a sputum Gram stain suggests that...

Which of the following best describes this field from a urine Gram stain?

Which of the following best describes this image of a wound Gram stain?

What can be determined from the results of this Gram stain from a stool specimen?
A) The patient has proctitis.
B) The patient has food poisoning.
C) The patient has an ulcer.
D) The patient is infected with a parasite.
E) None of the above

This cerebrospinal fluid specimen from a 33 year old male suggests which of the following?

This cell is most likely a ...

Which of the following best describes this image from a sputum Gram stain?

Which of the following best describes this image of a joint fluid Gram stain?
This image was most likely taken from what specimen site?

Which of the following best describes this image of a Gram stained urine specimen?

Which of the following best describes this image of a wound Gram stain?

Which of the following best describes this image of a Gram stained wound specimen?


 Hide known cards
Hide known cards